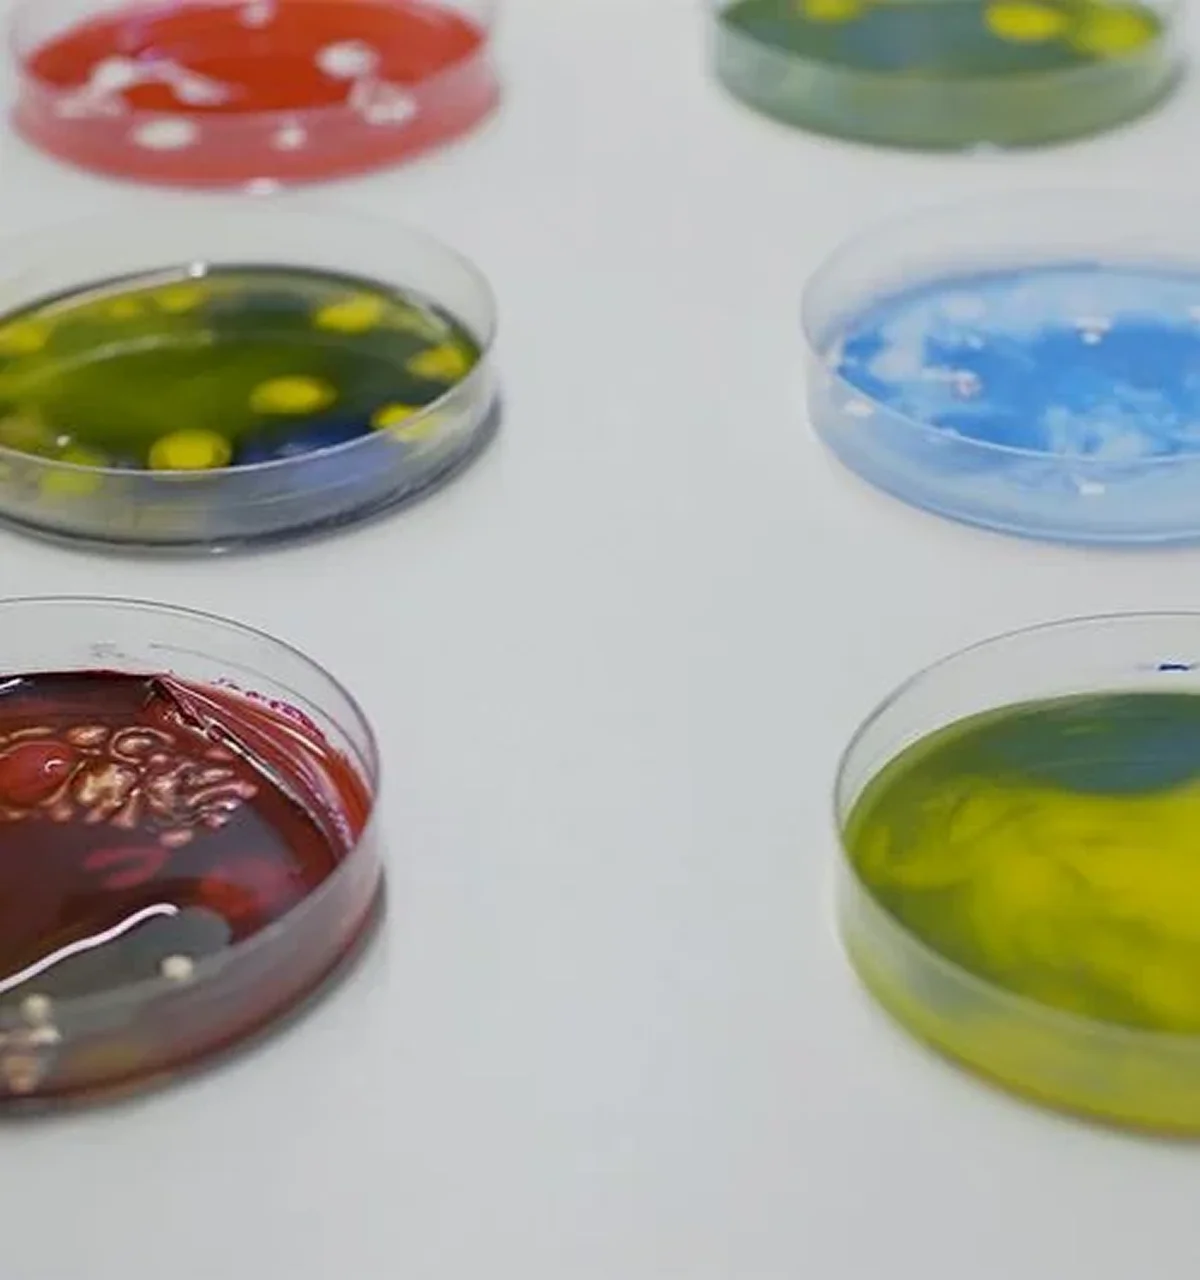

Training Experts in the Miracle of Life Leading education, innovation, & Compassionate care in clinical embryology & reproductive medicine.
Trainers with
Years Of
Experience
Trained Professionals
State of the Art Laboratories
Global
Collaborations
Dedicated to the Training of Life’s First Responders
The Rigen Academy of Clinical Embryology and Reproductive Medicine is a premier academic institution and a center of clinical excellence dedicated to advancing the science and art of in vitro fertilization (IVF), advanced assisted reproduction, and embryology.

Academic Programs
M.Sc. in Clinical Embryology
2 Year
Designed For
Aspiring embryologists and life science graduates seeking advanced academic and practical training in human embryology, assisted reproductive technology (ART), and IVF lab techniques.
Overview
A two-year postgraduate program that blends rigorous academic study with immersive hands-on training in clinical embryology. The curriculum is tailored to build deep scientific knowledge, laboratory competence, and research capabilities to shape professionals in the growing field of ART.
Ideal Audience
- Postgraduates in Life Sciences (e.g., Zoology, Biochemistry, Microbiology)
- MBBS graduates
- Bachelor’s/Master’s in Veterinary Science
- Master’s in Biotechnology
- BSMS/BNYS or any alternative Indian medicine systems from a recognized university
Program Details
- Duration: 2 Years (Full-time).
- Course Fee: INR 6,50,000 + taxes as applicable.
- Eligibility: Relevant undergraduate or postgraduate degree as listed above.
- Course Structure: Academic coursework + Lab training + Clinical exposure.
- Thesis Requirement: One original research thesis to be completed and defended in the final year
- Certification: M.Sc. awarded upon successful completion of all coursework, lab competencies, thesis, and evaluations.
Highlights
- Strong foundation in reproductive biology, embryology, endocrinology, and ART techniques
- Practical training in semen analysis, sperm preparation, ICSI, embryo culture, and cryopreservation
- Exposure to embryology labs, IVF procedures, and regulatory practices
- Research-driven approach with guided thesis work and scientific writing mentorship
- Continuous academic engagement through seminars, case studies, and journal clubs
- Ethical and regulatory training aligned with ART and PCPNDT guidelines
View All Details
- Build your career as a clinical embryologist with a globally relevant, future-ready M.Sc. program.
Fellowship in Reproductive Medicine
1 Year
Designed For
Qualified obstetricians and gynecologists aiming to specialize in advanced infertility care, assisted reproductive technologies (ART), and comprehensive reproductive healthcare.
Designed For
A one-year intensive fellowship offering in-depth clinical and academic training in reproductive medicine and ART. The program integrates hands-on skills, research, and real-time exposure to advanced fertility treatments to develop future leaders in the field.
Ideal Audience
- MD/MS in Obstetrics & Gynecology
- DNB in Obstetrics & Gynecology
- DGO (Diploma in Obstetrics & Gynecology)
Program Details
- Duration: 1 Year (Full-time)
- Course Fee: INR 8,50,000 + taxes as applicable
- Eligibility: Relevant undergraduate or postgraduate degree as listed above.
- Eligibility: Postgraduate qualification in Obstetrics & Gynecology (MD/MS/ DNB/DGO)
- Thesis Requirement: One original research thesis to be completed and submitted before course completion
- Certification: Fellowship awarded upon successful completion of training, clinical logbook, thesis submission, and final evaluations
Highlights
- In-depth training in infertility diagnosis, ovarian stimulation, IUI, IVF, ICSI, cryopreservation, and preimplantation genetic testing
- Hands-on experience in ovum pickup, embryo transfer, ultrasound monitoring, and lab techniques
- Dedicated clinical rotations at high-volume IVF and ART centers
- Strong academic foundation through seminars, journal clubs, and case reviews
- Thesis development under expert faculty guidance
- Emphasis on ethical practice, patient counseling, and compliance with ART regulations in India
View All Details
IVF & ICSI Techniques
3 Months
Designed For
Aspiring and practicing embryologists seeking structured training in IVF lab procedures and intracytoplasmic sperm injection (ICSI).
Overview
A 3-month immersive program providing hands-on learning in embryology workflows, micromanipulation techniques, and embryo culture.
Ideal Audience
- Postgraduates in Life Sciences (preferably M.Sc. Clinical Embryology)
- Candidates with prior embryology experience
Program Details
- Duration: 3 Months
- Course Fee: INR 2,50,000
- Certification: Issued upon successful completion and assessment
Highlights
- Sperm preparation, oocyte retrieval, ICSI micromanipulation, and embryo grading
- Cryopreservation and thawing techniques
- IVF lab setup, quality control, and record maintenance
- One-on-one mentorship and continuous evaluation
- Complimentary online conference registration
View All Details
Andrology & Semen Processing
10 Days
Designed For
Professionals aiming to specialize in male infertility diagnostics and advanced semen processing.
Overview
A 10-day focused course covering complete andrology lab skills, including semen analysis and troubleshooting techniques to improve fertility outcomes.
Ideal Audience
- Postgraduates in Life Sciences
- Practicing andrologists and embryologists
Program Details
- Duration: 10 Days
- Course Fee: INR 50,000
- Certification: Issued upon completion and validation exam
Highlights
- Semen collection, analysis, and preparation for IUI, IVF, and ICSI
- Advanced assessment techniques (DFI, MACS, PICSI)
- Cryopreservation and thawing of sperm
- Troubleshooting to improve IUI success rates
- Free online conference registration
View All Details
Calendar of Events
Training & Workshops
Sharpen your skills through immersive, practical learning experiences. Our programs are designed to bridge theory and practice, helping professionals grow with confidence under expert mentorship.
- Hands-on IVF Lab Training
- Short-Term Intensive Courses
- International Observerships
- Simulation-Based Learning Modules
Research & Publications
Fostering a culture of inquiry and innovation.
We support meaningful exploration that contributes to advancing knowledge in reproductive and life sciences.

Ongoing Research Projects
Collaborations with Universities

Recent Publications

Student Thesis Repository
Campus & Acilities
Our campus blends modern infrastructure with practical spaces that support focused learning, collaboration, and research.
State-of-the-art IVF & Embryology Labs
Research Library
Audio-Visual Classrooms
Research Library
Application Process
Important
Dates
Online Application Form
Fee Structure
Scholarships
International Student Info
Admissions
Explore available programs, check eligibility, and apply with ease through our structured admission process.